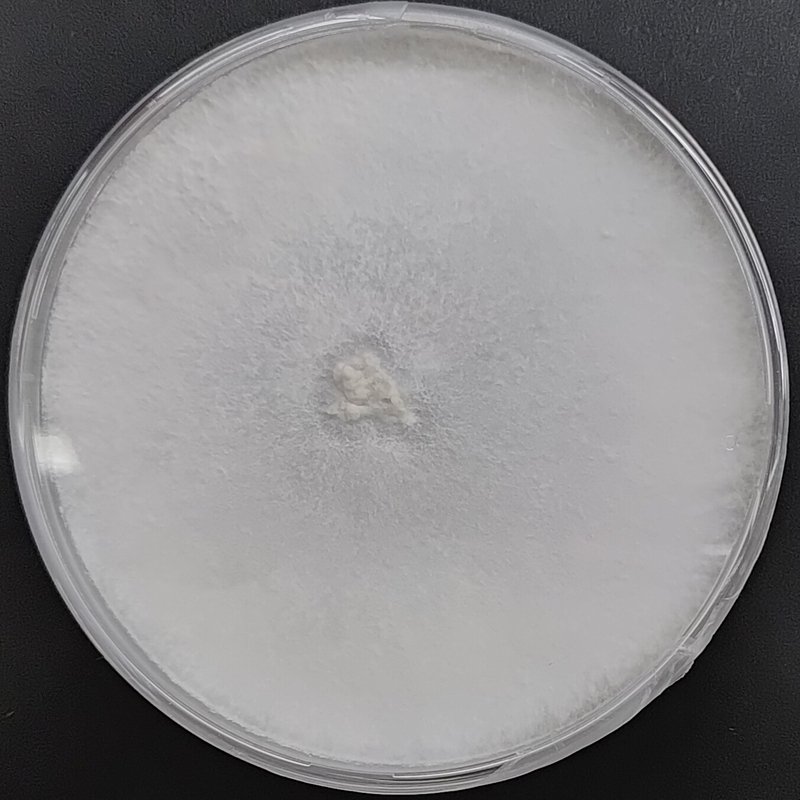

Trametes versicolor (Turkey Tail) – Pure Culture Plate
The Trametes versicolor (Turkey Tail) – Pure Culture Plate provides a verified, contamination-free strain ideal for both scientific study and commercial mycology. Turkey Tail is a globally recognized medicinal mushroom valued for its immunomodulatory and antioxidant compounds, especially PSK and PSP.
This pure culture plate offers rapid colonization, stable growth, and excellent adaptability across substrates such as hardwood sawdust and agar media.
Features:
Authentic Trametes versicolor strain (Turkey Tail)
Ideal for medicinal and research applications
Vigorous, fast-spreading mycelium
Rich in natural polysaccharides and beta-glucans
100% pure, lab-tested culture for consistent performance
Perfect for researchers, cultivators, and mycology enthusiasts seeking a premium-quality Turkey Tail strain for culture work or spawn preparation.

|
| 
